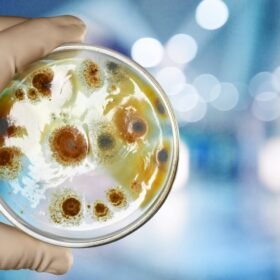

Šiandienos geopolitinė aplinka, ypač po Rusijos invazijos į Ukrainą, verčia Europos valstybes kritiškai įvertinti savo gynybos pajėgumus ir saugumo strategijas. Šiame kontekste Europos saugumas tapo ne tik diskusijų, bet ir neatidėliotinų veiksmų objektu. Ekspertai vis garsiau kalba apie būtinybę didinti gynybos finansavimą ir stiprinti karines pajėgas, siekiant užtikrinti regiono stabilumą ir atsparumą galimoms grėsmėms.
Būtinybė Stiprinti Europos Karines Pajėgas ir Gynybos Finansavimą
R. Kauno teigimu, siekiant, kad NATO išliktų galinga ir pasirengusi atremti grėsmes, būtina stiprėjanti Europos sąjungininkų karinė galia ir patikimi JAV saugumo įsipareigojimai Europai. Jis pabrėžia, kad be realių veiksmų kalbos apie kolektyvinę gynybą liks tik žodžiais. Finansavimas yra pamatas, ant kurio statoma stipri gynyba. Dauguma NATO šalių yra įsipareigojusios skirti bent 2 procentus savo bendrojo vidaus produkto gynybai, tačiau šis tikslas dar nėra pasiektas visur. Jo pasiekimas ir viršijimas yra kritiškai svarbus, norint modernizuoti kariuomenes, įsigyti naujos įrangos ir užtikrinti personalo pasirengimą.
„Europos šalys turi aiškiai parodyti, kad įgyvendina savo įsipareigojimus – didinti gynybos finansavimą ir stiprinti karines pajėgas“, – ministerijos pranešime teigė R. Kaunas.
Šis įsipareigojimas reiškia ne tik daugiau pinigų, bet ir strateginę viziją – kaip šios lėšos bus panaudotos kuriant efektyvias, interoperabilias ir greitai dislokuojamas pajėgas, galinčias veikti kartu su sąjungininkais. Tai apima investicijas į aukštąsias technologijas, kibernetinę gynybą, oro gynybos sistemas ir logistiką, kurios yra gyvybiškai svarbios šiuolaikiniame kare.
Transatlantinių Ryšių Svarba ir JAV Įsipareigojimai
Nors Europa turi prisiimti didesnę atsakomybę už savo gynybą, transatlantinis ryšys su Jungtinėmis Amerikos Valstijomis išlieka nepakeičiamas. JAV įsipareigojimai Europai yra NATO kolektyvinės gynybos pagrindas, o jų patikimumas tiesiogiai veikia visos Aljanso atgrasymo galią. Tačiau stipresnė ir savarankiškesnė Europos gynyba tik sustiprintų šį ryšį, paverčiant jį tikra dvipuse gatve, kurioje abi pusės prisiima adekvačią naštą.
Tai padidintų viso Aljanso atgrasymo potencialą ir parodytų vienybę bei ryžtą bet kokios agresijos akivaizdoje.Poveikis Regiono Saugumui ir Ateities Perspektyvos
Europai aktyviai stiprinant savo gynybinius pajėgumus, ilgalaikė nauda bus akivaizdi. Tai ne tik užtikrins didesnį regiono stabilumą, bet ir padidins gebėjimą savarankiškai reaguoti į krizes, sumažinant priklausomybę nuo išorės pagalbos. Stipresnė gynyba yra geriausia prevencija ir atgrasymo priemonė, siunčianti aiškų signalą potencialiems agresoriams. Europos lyderių valia ir ryžtas investuoti į saugumą šiandien nulems žemyno ateitį ir jo poziciją globalioje arenoje.

Martyna Baranauskaitė – autorė, rengianti skaitytojams aktualų ir įdomų turinį įvairiomis temomis. Jos straipsniuose daug dėmesio skiriama aiškumui, informatyvumui ir sklandžiam pateikimui, kad skaitytojai greitai rastų naudingą ir suprantamai pateiktą informaciją.